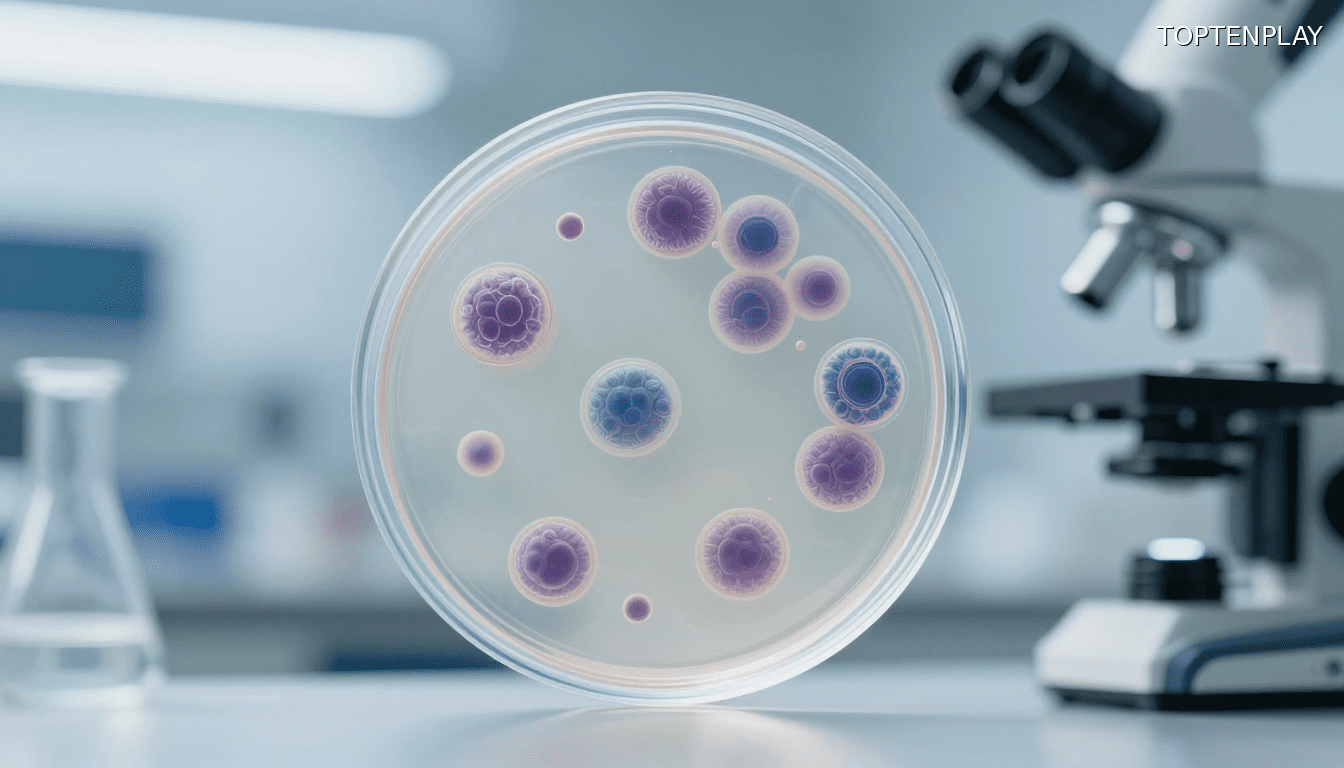
Image d'illustration © TopTenPlay

📌 VIH : sept ans sans traitement, ce qui s’est produit dans son corps défie tout ce qu’on croyait savoir
Posted 7 décembre 2025 by: Admin

Un Cas Médical Qui Bouscule Les Certitudes Scientifiques
En 2015, un homme porteur du VIH reçoit une greffe de cellules souches pour traiter sa leucémie. Neuf ans plus tard, il vit sans trace détectable du virus depuis plus de sept ans, sans aucun traitement antirétroviral. Cette rémission totale intrigue la communauté scientifique pour une raison décisive : contrairement aux rares cas de guérison documentés jusqu’ici, ce patient n’a pas bénéficié d’une protection génétique complète contre le VIH.
Les guérisons précédentes reposaient sur des greffes de cellules entièrement dépourvues du gène CCR5, codant une protéine essentielle à l’entrée du virus dans les cellules immunitaires. Faute de donneur totalement compatible, ce patient a reçu des cellules ne présentant qu’une seule copie mutée du gène, une configuration théoriquement imparfaite. Trois ans après la greffe, il décide d’interrompre volontairement son traitement. Aucun rebond viral ne survient.
Le professeur Christian Gaebler, de la Charité à Berlin, suit de près cette évolution exceptionnelle. « Ce cas démontre qu’une guérison est possible même sans mutation CCR5 complète », explique-t-il. Cette observation oblige les chercheurs à revoir leurs modèles théoriques. D’autres mécanismes, encore mal compris, semblent capables d’éliminer durablement le virus : destruction ciblée des cellules infectées résiduelles, intégration ultrarapide des cellules du donneur, ou réponses immunitaires inédites. Une piste s’ouvre vers des stratégies de guérison bien plus larges que prévu.
Les Mécanismes Invisibles D’une Guérison Inattendue
Cette rémission sans mutation complète révèle des processus biologiques que la science n’avait pas encore identifiés. L’équipe de la Charité concentre désormais ses efforts sur l’analyse des mécanismes alternatifs qui ont permis l’élimination du virus. Deux hypothèses principales émergent : soit le système immunitaire reconstruit a systématiquement détruit les cellules porteuses du VIH, soit les cellules greffées se sont intégrées si rapidement qu’elles ont empêché toute niche de survie virale.
Les chercheurs examinent également la possibilité que des réponses immunitaires atypiques, non détectées par les outils diagnostiques standards, aient joué un rôle déterminant. Contrairement aux modèles établis, la simple présence d’une copie mutée du gène CCR5 ne suffit pas à expliquer une rémission de cette ampleur. D’autres facteurs, probablement liés à la dynamique de la greffe ou à des interactions cellulaires spécifiques, ont contribué au succès thérapeutique.
Cette découverte élargit considérablement le champ des possibles. Si une guérison peut survenir sans protection génétique totale, alors les stratégies futures ne dépendent plus uniquement de la recherche d’un donneur porteur d’une double mutation CCR5. Les travaux de Christian Gaebler visent désormais à identifier précisément ces facteurs protecteurs pour les reproduire artificiellement, sans recourir aux risques vitaux d’une greffe. L’objectif : transformer cette exception médicale en modèle applicable à d’autres patients.

Les Contrôleurs Post-Traitement, Une Piste Naturelle Vers La Cure
Au-delà de ce cas exceptionnel, la recherche identifie des profils encore plus surprenants : des contrôleurs post-traitement qui maintiennent le virus indétectable après l’arrêt complet des antirétroviraux, sans greffe ni mutation génétique. Leur système immunitaire contient naturellement le VIH de manière stable, comme si l’infection était figée dans un état d’équilibre durable. Ces personnes représentent des modèles vivants de rémission à long terme, démontrant qu’une guérison fonctionnelle existe en dehors de tout protocole expérimental lourd.
Les observations révèlent chez eux des réponses immunitaires atypiques, renforcées par l’administration de nouveaux anticorps thérapeutiques. Cette stabilité immunitaire intrigue particulièrement l’équipe de Gaebler, qui y voit une voie alternative pour reproduire artificiellement cet état protecteur. L’objectif : mimer ces mécanismes naturels sans exposer les patients aux dangers d’une greffe de cellules souches, procédure réservée aux cancers du sang en raison de ses risques vitaux considérables.
La Charité explore désormais des approches thérapeutiques capables d’induire ce type de réponse immunitaire contrôlée. Immunomodulation, anticorps de nouvelle génération ou édition génétique ciblée figurent parmi les pistes concrètes. Ces stratégies visent à transformer des situations exceptionnelles en traitements accessibles, offrant une rémission durable sans les contraintes d’une intervention aussi lourde qu’une transplantation.

Des Avancées Prometteuses Entre Espoir Et Réalisme Médical
Ces découvertes fascinent, mais la réalité médicale impose ses limites. La greffe de cellules souches reste réservée aux cancers du sang, ses risques vitaux la rendant inadaptée pour traiter le VIH seul. Pour l’immense majorité des 39 millions de personnes vivant avec le virus, les traitements antirétroviraux quotidiens ou les injections à longue durée d’action demeurent les options les plus sûres. Les progrès récents offrent déjà des solutions concrètes : certains traitements ne nécessitent désormais que deux injections annuelles, libérant les patients de la contrainte quotidienne.
L’équipe de Gaebler concentre ses efforts sur la compréhension précise des facteurs permettant une rémission profonde. Leur ambition : transformer ces cas exceptionnels en approches thérapeutiques accessibles, sans les dangers d’une transplantation. Immunomodulation ciblée, anticorps de synthèse ou édition génétique pourraient reproduire artificiellement les mécanismes observés chez les contrôleurs naturels, ouvrant une voie vers une cure du VIH moins invasive.
Chaque rémission documentée révèle qu’aucune stratégie unique ne s’impose. Le parcours de cet homme prouve qu’un mécanisme encore mal identifié peut éliminer durablement le virus sans protection génétique complète. Cette multiplicité de voies constitue une force : elle démontre que plusieurs chemins thérapeutiques restent à explorer avant d’atteindre une guérison accessible au plus grand nombre.










